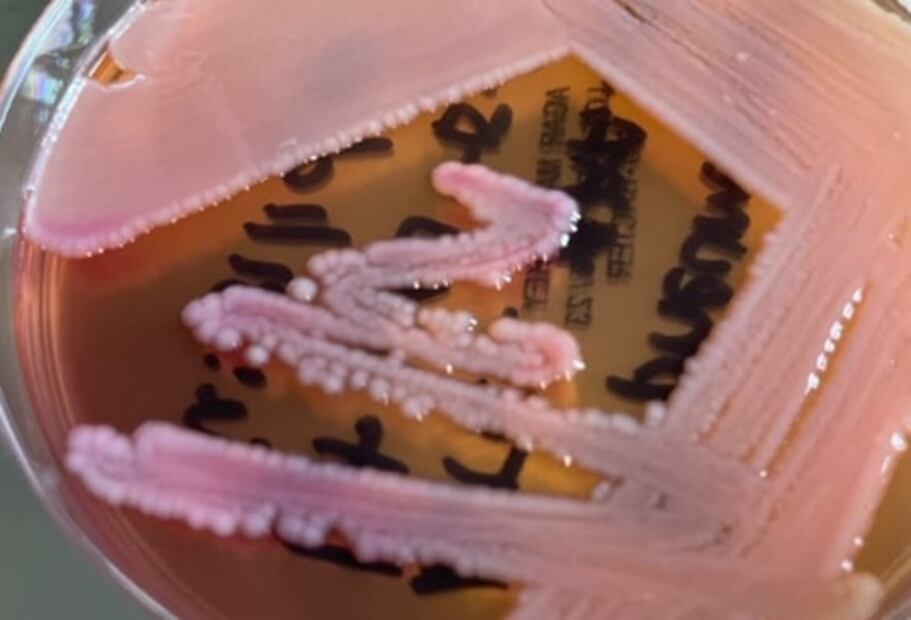

El combate contra las bacterias ha sido una batalla sin fin que la humanidad ha tenido con el objetivo de poder hacerle frente sin ningún problema a todos los retos que la naturaleza le ponga.
Las pandemias, que han borrado millones de vidas a lo largo de la historia, hicieron que la humanidad hiciera esfuerzos en conseguir superar la adversidad, gracias a la innovación, la ciencia, la tecnología y el instinto de supervivencia.
El avance del tiempo ha permitido que haya una mayor maniobrabilidad al momento de combatir enfermedades mortales, pues los tratamientos médicos o las vacunas han servido para que el hombre se sienta fortalecido y protegido.
Lee también: De lo micro a lo macro, la ciencia que viene
Sin embargo, aún con la tecnología de punta que hay en el presente, una nueva y rara enfermedad puso al mundo patas arriba, haciendo caer a muchos en el fatalismo y en el fin, pues el temor y respeto a la naturaleza siguen en vigencia, y una prueba de ello es la cantidad de enfermedades que, pese a que son manejables, no dejan de ser un riesgo latente de muerte para muchos.
La revista médica ‘The Lancet’ asegura que cinco bacterias fueron responsables de la muerte de 1,27 millones de personas en el año 2019. Este estudio se realizó con datos de 471 millones de personas de 204 países diferentes y se tuvieron en cuenta 23 patógenos y 88 combinaciones de enfermedades y medicamentos.
Estafilococo áureo
La staphylococcus aureus es una de las principales bacterias causantes de infecciones en la piel y los tejidos blancos, tales como abscesos, infecciones por estafilococos y celulitis en la cara o en el cuello.
Su propagación se da principalmente por contacto de heridas quirúrgicas, aunque también se puede transmitir a través de la ingesta de alimentos, los cuales pueden provocar vómito, diarrea y cólicos.
También puede provocar neumonía, osteomielitis, peritonitis, ántrax o el síndrome de coagulación intravascular diseminada, la cual puede ser mortal si no se trata a tiempo, según la Biblioteca Nacional de Medicina de los Estados Unidos.
Lee también: Programa para enfrentar riesgos epidemiológicos
E. coli

Foto: Twitter
La escherichia coli tiene mayor actividad en el sistema digestivo, pues puede provocar dolor intenso en el estómago, diarrea (en los peores casos, con sangre) e insuficiencia renal.
Esta bacteria tiene presencia permanente en el intestino grueso y en la materia fecal de muchos animales. Sus efectos negativos se pueden agudizar al consumir comida contaminada, tocando animales muertos o nadando en agua sucia, de acuerdo con la Academia Americana de Pediatría.
Neumococo

Foto: Twitter
Este microorganismo es responsable de infecciones en los oídos y los senos paranasales. También puede provocar neumonía e infecciones en el torrente sanguíneo.
De acuerdo con la Asociación Española de Pediatría, este se encuentra presente en la laringe y la lengua de muchos niños, cuestión que provocó la creación de una vacuna aplicable a personas menores de edad. Principales en edades de la primera infancia (cero a cinco años).
Klebsiella pneumoniae
Foto: Twitter
Esta bacteria es responsable de varias infecciones en el tracto urinario, así como neumonías, sepsis, infecciones de heridas quirúrgicas y de tejidos blandos. Es muy común que los pacientes ingresados a cuidados intensivos, alcohólicos y bebés recién nacidos la contraigan.
También es común encontrarla en cirugías en la caja torácica o para la revascularización coronaria. Así como el estafilococo áureo, tiene resistencia a los antibióticos fuertes como la penicilina, además de las cefalosporinas, según la investigación llamada ’Klebsiella pneumoniae como patógeno intrahospitalario: epidemiología y resistencia’ de los microbiólogos Lina María Echeverri Toro y Juan Carlos Cataño Correa.
Pseudomonas aeruginosa
Esta bacteria habita comúnmente en el suelo y en el agua subterránea y afecta, principalmente, a las personas que tienen sus defensas bajas. Es responsable de infecciones respiratorias y sanguíneas. El contacto con agua contaminada es su principal canal de transmisión, de acuerdo con el portal de los Centros para Control de Enfermedades e Infecciones de los Estados Unidos.
Se aloja en sitios como la boca y el esputo, en los cuales tiene las condiciones ideales para una colonización o retoño sin infección creciente; y sirve como un aviso por parte del médico microbiólogo o infectólogo para empezar un tratamiento inmediato.
Es resistente a una gran cantidad de familias de antibióticos. Sin embargo, el tratamiento que se haga con estos puede hacer variar su efectividad, como los que son asignados de forma empírica. Estos medicamentos deben ser aplicados mediante inyección.
Suscríbete aquí para recibir directo en tu correo nuestras newsletters sobre noticias del día, opinión, planes para el fin de semana.
melc